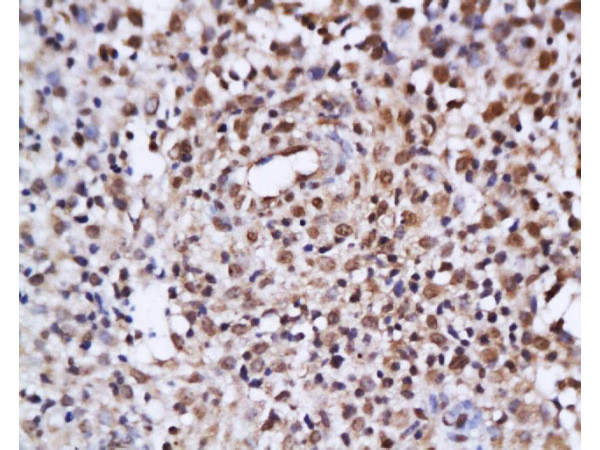
Estrogen Receptor alpha + beta Antibody in Immunohistochemistry (Paraffin) (IHC (P))

Search
Bioss
Estrogen Receptor alpha + beta Polyclonal Antibody
{{$productOrderCtrl.translations['antibody.pdp.commerceCard.promotion.promotions']}}
{{$productOrderCtrl.translations['antibody.pdp.commerceCard.promotion.viewpromo']}}
{{$productOrderCtrl.translations['antibody.pdp.commerceCard.promotion.promocode']}}: {{promo.promoCode}} {{promo.promoTitle}} {{promo.promoDescription}}. {{$productOrderCtrl.translations['antibody.pdp.commerceCard.promotion.learnmore']}}
产品信息
BS-0174R
种属反应
宿主/亚型
分类
类型
抗原
偶联物
形式
浓度
规格
纯化类型
保存液
内含物
保存条件
运输条件
靶标信息
The estrogen receptor (ER) is a 66 kDa protein that mediates the actions of estrogens in estrogen responsive tissues. It is a member of a large superfamily of nuclear hormone receptors that function as ligand activated transcription factors. The ER gene consists of more than 140 kb of genomic DNA divided into 8 exons. These translate into a protein with six functionally discrete domains, labeled A through F. A second form of the estrogen receptor, ER beta has recently been described. The ER is an important regulator of growth and differentiation in the mammary gland. Presence of ER in breast tumors indicates an increased likelihood of response to anti estrogen (e.g. tamoxifen) therapy.
仅用于科研。不用于诊断过程。未经明确授权不得转售。
篇参考文献 (0)
生物信息学
蛋白别名: E2 receptor alpha; ER; Er alpha; ER beta; ER delta E7 isoform; ER-alpha; ER-alpha; del.3*,+1*,4,5,6,7* variant; ER-alpha; del.3*,4,5,6,7*/770 variant; ER-alpha; del.3*,4,5,6,7,8*/862 variant; ER-alpha; del.4*,5*,7 variant; ER-alpha; del.4*,5,6*/548 variant; ER-alpha; del.4*,5,6,7*/714 variant; ER-alpha; del.4*,5,6,7,8*/754 variant; ER-alpha; estrogen receptor alpha delta 3*,4,5,6,7*/819 cingulate gyrus isoform; ER-alpha; estrogen receptor alpha delta 3*,4,5,6,7*/833 superior frontal gyrus isoform; ER-alpha; estrogen receptor alpha delta 4*,5,6,7*/747 substantia nigra isoform; ER-beta; ERbeta 4; Estradiol receptor; estrogen nuclear receptor alpha; Estrogen receptor; estrogen receptor 1 (alpha); estrogen receptor 2 beta; estrogen receptor alpha c-terminus splice variant 1-2; estrogen receptor alpha E1-E2-1-2; estrogen receptor alpha E1-N2-E2-1-2; estrogen receptor alpha variant delta 4; Estrogen receptor beta; estrogen receptor beta 2; estrogen receptor beta 4; estrogen receptor protein; estrogen receptor-related protein; lacks a part of the exon 3, exons 4-6, and part of exon 7; contains an 822 base in frame deletion; lacks most of the exon 3, exons 4-7, and part of exon 8; lacks most of the exon 4, exons 5-6, and part of exon 7; lacks the end of the exon 3, exons 4-7, and part of exon 8; MB1; nuclear receptor; Nuclear receptor subfamily 3 group A member 1; Nuclear receptor subfamily 3 group A member 2; oestrogen receptor alpha; oestrogen receptor beta; receptor; splice variant; steroid hormone receptor; unnamed protein product
基因别名: ER; ER-alpha; ER-BETA; ER[b]; ERa; ERalpha; Erb; Erb2; ERbeta; ESR; ESR-BETA; ESR1; ESR2; ESRA; ESRB; Estr; Estra; ESTRB; ESTRR; NR3A1; NR3A2; ODG8; RNESTROR
UniProt ID: (Human) P03372, (Human) Q92731, (Mouse) P19785, (Rat) P06211, (Mouse) O08537, (Rat) Q62986
Entrez Gene ID: (Human) 2099, (Human) 2100, (Mouse) 13982, (Rat) 24890, (Mouse) 13983, (Rat) 25149